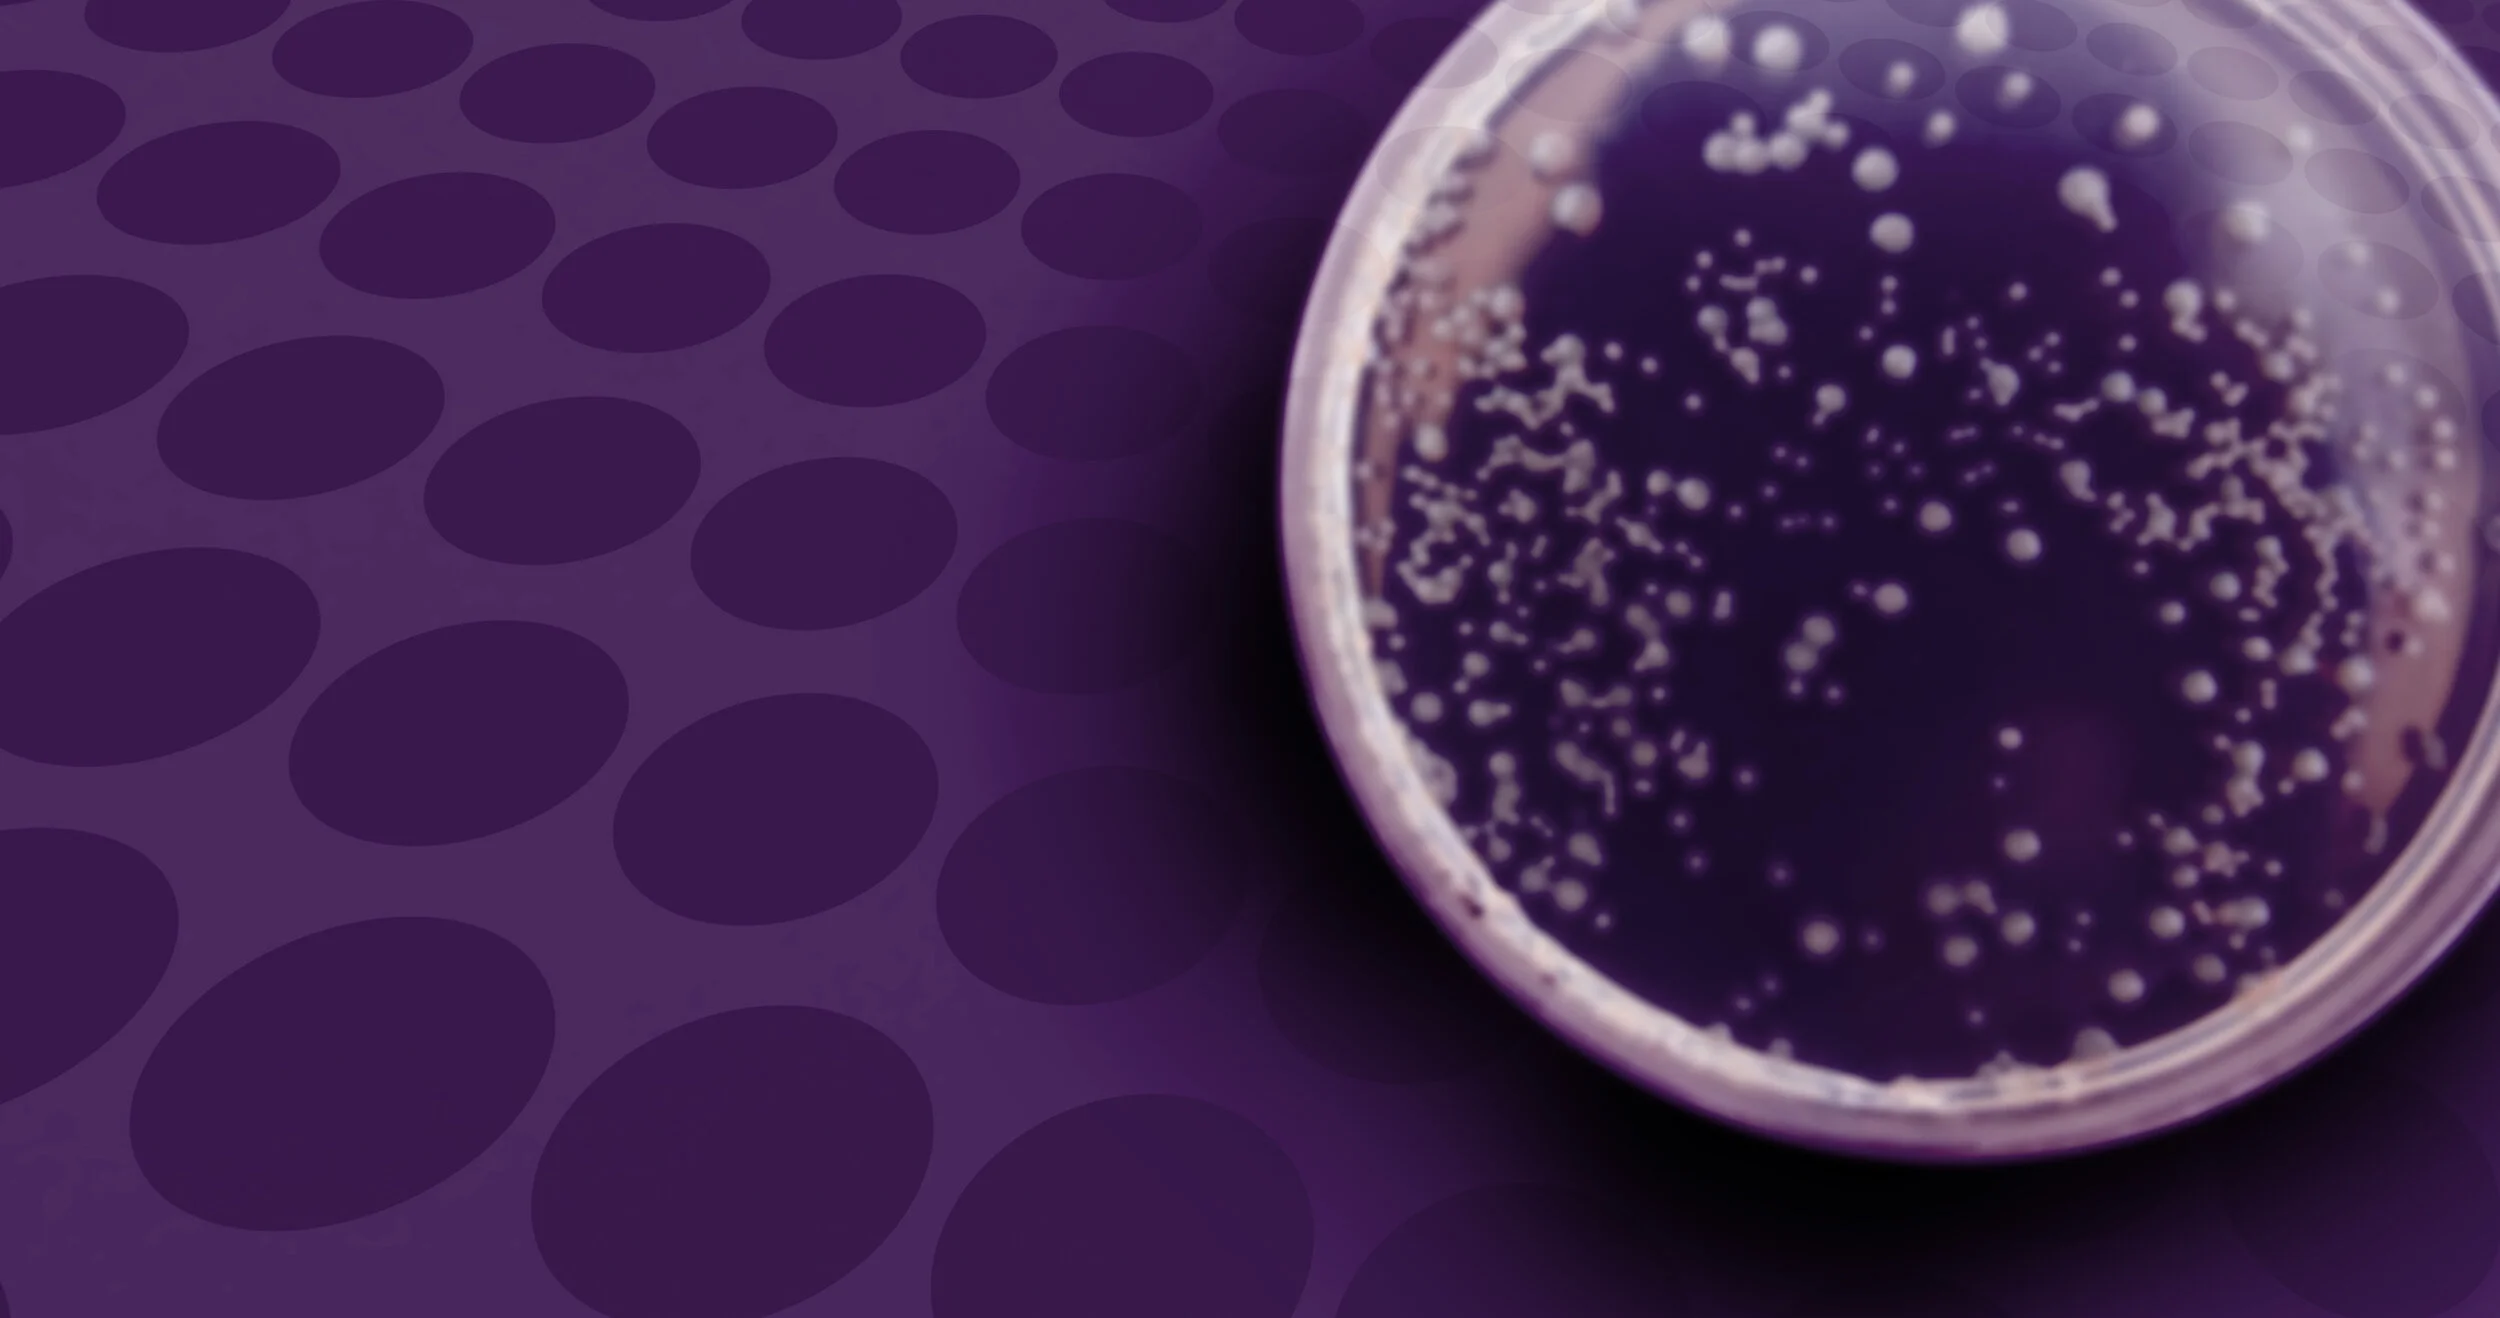

About the host
Randene Neill spent two decades as an award winning journalist at BCTV and Global News, covering stories, events and news that affected British Columbians and Canadians. In 2016, she made the tough decision to step away from daily news to pursue other opportunities. Currently, she is working on the new St. Paul’s Hospital and Health Campus Project.











